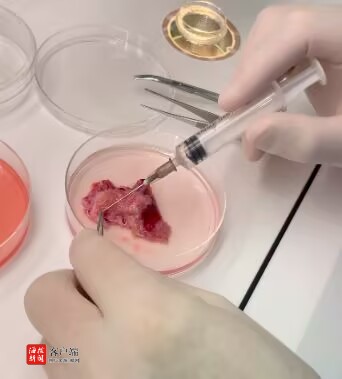

全国首例!海医一附院生殖医学中心实现卵巢肿瘤患者“妈妈梦”

全国首例!海医一附院生殖医学中心实现卵巢肿瘤患者“妈妈梦”

全国首例!海医一附院生殖医学中心实现卵巢肿瘤患者“妈妈梦”
商报全媒体讯(椰网/海拔新闻记者 孙鑫 通讯员 姚宇飞 江欣星)在海南医科大学第一附属医院(以下简称:海医一附院)生殖医学中心的胚胎实验室里,三枚胚胎静静沉睡着,宛如三粒蕴含无限可能的生命种子。这三枚胚胎,承载的不只是医学上的突破,更是一位母亲跨越生死考验的勇气见证。这是全国首例由两家医院协同完成并采用近生理温度转运离体卵巢组织,为卵巢肿瘤患者成功实施生育力保存并成功生育的案例。这一案例不仅为卵巢肿瘤患者点亮了生育希望,也为全国范围内的生育力保存技术的发展和应用提供了宝贵的经验,具有重要的临床意义和示范价值。

病魔突袭:希望之光渐黯
小夏(化名)是一位年仅20多岁的已婚未育女性,青春正好。然而2021年初的一次常规超声检查却打破了她平静的生活。超声提示盆腔包块,不排除她患有卵巢肿瘤的可能,医生建议手术治疗。于是小夏怀着忐忑的心情,前往海南省人民医院,找到了妇科主任朱根海教授,朱教授亲自操刀,为小夏进行了右侧附件切除术与左侧卵巢肿瘤切除术。虽然手术十分成功,但术后冰冷的确诊结果提示:双侧卵巢肿瘤,这如同一把利刃,刺进了小夏和爱人的心间。他们的生活轨迹也自此被彻底改写,曾经对未来的美好憧憬,瞬间化为泡影。
2022年3月,命运的重击再次袭来,在术后一年复查B超显示,小夏左侧卵巢又出现了囊实性包块,提示肿瘤二次复发,这个消息如乌云般再次笼罩这个伤痕累累的家庭。小夏脆弱的生命之舟上仿佛被凿开一个洞,随着时间流逝,消弭的不只是身体的健康,还有孕育生命的能力。由于海南省人民医院与海医一附院一直保持着紧密的学术交流与临床合作,考虑到肿瘤对卵巢和生育力的损伤情况,朱根海主任建议小夏术前联系该院生殖中心主任马燕琳教授对生育力保存相关事宜进行咨询,以便早做打算。此时,小夏与爱人痛苦不堪,这对年轻夫妻,在生存与求子之路上,似乎已陷入绝境。

艰难抉择:生育力保存之困
当下,小夏所面对的选择已经迫在眉睫:究竟该全力投入拯救生命的肿瘤治疗,还是冒险尝试保存生育能力,为未来留一丝希望?这不仅是与病魔的较量,更是在身体健康和生育能力之间痛苦权衡的艰难博弈。就在小夏陷入无尽的迷茫与绝望时,她第一时间来到了该院生殖中心寻求帮助,马燕琳教授凭借着丰富的临床经验和敏锐的医学洞察力,迅速联合多学科专家,为小夏量身定制解决方案,设身处地的给出合理的治疗建议。
“卵巢手术无可避免,但我们可以尝试在术中获取卵巢组织,紧急保存你的生育能力,让治疗与希望并存。”马燕琳教授坚定的话语给了这个苦难家庭一丝希望,命运的转机悄然而至。
曙光乍现:生殖中心显身手
考虑到小夏的艰难处境,马燕琳主任组织多次会诊,带领专家们深入研究小夏病情,不放过任何细节。在该医院科室全力帮助下,小夏也逐渐从迷茫与恐惧中走出,鼓起勇气,准备直面这场艰难挑战。
为完成这一创举,两家医院携手合作,开启了一场生命接力。2022年5月,朱根海主任再次为小夏进行了手术。而马燕琳教授团队胚胎实验室成员则早早地来到手术室外严阵以待,手术切除离体后的卵巢组织被立即放入组织转运液中恒温保存。承载着小夏最后生育希望的卵巢组织,被胚胎实验室成员第一时间从海南省人民医院精准运送至该院生殖中心。
胚胎实验室主任张宇博士早已等候多时,他凭借深厚专业知识和丰富经验亲自把控后续关键步骤,带领胚胎学家姚宇飞和黄艳华先对离体的卵巢组织进行卵泡抽吸,接着对卵巢组织进行切割,最终在高倍显微镜下收集到7枚游离出来的未成熟卵母细胞。再利用中心领先的卵母细胞体外成熟技术,对卵母细胞进行精心的呵护与培养。功夫不负有心人,最终成功获得4枚成熟卵子。通过体外卵胞质内单精子注射技术,幸运地得到3枚可利用胚胎。当这个消息传来,整个科室都为之振奋。这3枚胚胎,如黑暗中的璀璨星辰,为小夏保留了孕育下一代的希望,也让她重新燃起对生活的热情。

奇迹降临:新生命的绽放
手术之后,紧接着6个周期的辅助化疗开始。每次化疗,小夏都承受着身体的剧烈不适,但她眼神中始终闪烁着坚定的光芒,为那一丝孕育的希望努力抗争。化疗结束7个多月后,小夏复查肿瘤六项正常,阴道B超检查也未提示肿瘤复发倾向。这个消息,如春日第一缕阳光,温暖地洒在小夏及家属心头,让他们看到了黎明的曙光,小夏终于迎来胚胎移植的希望。
2024年6月,幸运之神降临,小夏通过胚胎移植手术终于怀孕了。2025年3月,一声清脆响亮的啼哭,宣告新生命的诞生。那一刻,小夏喜极而泣,她紧紧抱着自己的孩子,心中满是对生命的敬畏和对两院医疗团队的感恩。
据了解,这一成功案例,是国内首个通过近生理温度远距离转运离体卵巢组织并获得卵子进行培养、体外授精最终获得活产的病例,堪称海南省针对卵巢肿瘤患者实施生育力保存的典范之作,不仅是对海南医科大学第一附属医院生殖中心十余年深耕女性生育力保存领域探索的高度肯定,更是远距离卵巢组织转运流程的成功实践,有力彰显了科室间互联互通、医院间协同合作的显著成效。
【责任编辑:冯 超】
【内容审核:吴钟旺】
版权声明:国际旅游岛商报全媒体文字、图片、视频、音频等版权作品,欢迎转发,但非经本报书面授权同意,严禁包括但不限于转载或改编、引用等,违者必追究法律责任。